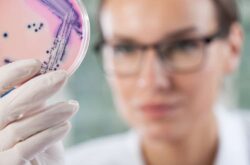
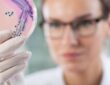

Με το συγκεκριμένο σχέδιο Π.Δ., δίνεται πλέον η δυνατότητα να διευρυνθεί ο αριθμός των εξειδικευμένων στην Κλινική Μικροβιολογία ιατρών Βιοπαθολόγων (πρώην Μικροβιολόγων), οι οποίοι εφόσον πληρούν τις νέες προϋποθέσεις, θα έχουν τη δυνατότητα να συμμετέχουν στις απαραίτητες εξετάσεις για την απόκτηση του αντίστοιχου τίτλου εξειδίκευσης,
«Με την τροποποίηση που επιφέρει το σχέδιο Π.Δ., δίνεται λύση σε ένα χρόνιο πρόβλημα με δεδομένο ότι έχουν παρέλθει 19 χρόνια από την έκδοση του Π.Δ. 386/1995. Σήμερα, ο αριθμός των εξειδικευμένων στην Κλινική Μικροβιολογία ιατρών δεν επαρκεί, οι ανάγκες παροχής εξειδικευμένων ιατρικών υπηρεσιών έχουν αυξηθεί, ενώ οι πρώτοι που απέκτησαν τη σχετική εξειδίκευση μέσω μεταβατικών διατάξεων έχουν αποχωρήσει από το ΕΣΥ, με αποτέλεσμα να μην υπάρχει επαρκής στελέχωση των Νοσοκομείων», αναφέρει το Υπουργείο Υγείας σε ανακοίνωση του.

Όροι και προϋποθέσεις για την εξειδίκευση στην Κλινική Μικροβιολογία
Περιοδικό Pharma & Health Business

Δημοφιλή
 Ποιος είναι ο Εμμανουήλ Φανδρίδης ο χειρουργός που ανέλαβε την επέμβαση της Μαρέβας Μητσοτάκη
Ποιος είναι ο Εμμανουήλ Φανδρίδης ο χειρουργός που ανέλαβε την επέμβαση της Μαρέβας Μητσοτάκη  Νέος τρόπος χορήγησης πρόσθετων αμοιβών στο ΕΣΥ
Νέος τρόπος χορήγησης πρόσθετων αμοιβών στο ΕΣΥ  Αναθεωρήθηκαν οι κατευθυντήριες Οδηγίες για τον Σακχαρώδη Διαβήτη
Αναθεωρήθηκαν οι κατευθυντήριες Οδηγίες για τον Σακχαρώδη Διαβήτη  Νοσοκομείο Σερρών: Προκηρύξεις για 11 νέους γιατρούς και εφαρμογή ηλεκτρονικού «βραχιολιού» στα Επείγοντα
Νοσοκομείο Σερρών: Προκηρύξεις για 11 νέους γιατρούς και εφαρμογή ηλεκτρονικού «βραχιολιού» στα Επείγοντα  Κλείσιμο μονάδας αιμοκάθαρσης στην Πιερία: 96 νεφροπαθείς σε καθημερινή ταλαιπωρία
Κλείσιμο μονάδας αιμοκάθαρσης στην Πιερία: 96 νεφροπαθείς σε καθημερινή ταλαιπωρία  Νέοι προσωρινοί διευθυντές στο Πανεπιστημιακό Παιδιατρικό Νοσοκομείο Θεσσαλονίκης «Ίδρυμα Σταύρος Νιάρχος»
Νέοι προσωρινοί διευθυντές στο Πανεπιστημιακό Παιδιατρικό Νοσοκομείο Θεσσαλονίκης «Ίδρυμα Σταύρος Νιάρχος»

Comments (0)